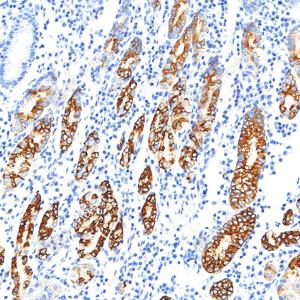
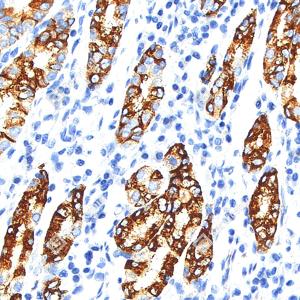

Recombinant Anti-MUC6 antibody (Rabbit mAb)
¥950
货号:YB150044-50
品牌:YIKE
规格:
- 50 μL
数量:
产品信息
蛋白质全称 | 粘蛋白6 |
别名 | MUC-6, Mucin 6, Gastric mucin-6 |
Uniprot ID | Q6W4X9 |
免疫原 | 人Mucin-6重组蛋白 |
抗体亚型 | IgG, κ |
克隆号 | SB279 |
纯化方式 | 亲和纯化 |
亚细胞定位 | 分泌型 |
应用
| 应用 | 物种 | 稀释 | 阳性样品 |
| IHC/IF 免疫组织化学/免疫荧光 | 人 | 1: 500-1: 1000 | 胃 |
背景
May provide a mechanism for modulation of the composition of the protective mucus layer related to acid secretion or the presence of bacteria and noxious agents in the lumen. Plays an important role in the cytoprotection of epithelial surfaces and are used as tumor markers in a variety of cancers. May play a role in epithelial organogenesis.
图像
| IHC检测MUC6蛋白(货号 GB150033). 样品: 人胃, 4%多聚甲醛 (货号G1101) 固定12-24小时. 抗原修复: 柠檬酸抗原修复液(干粉, pH 6.0) (G1201), 高压锅均匀喷气计时2分钟. —抗: 1: 800稀释, 4℃ 孵育过夜. 二抗: S-vision免疫组化多聚二抗(山羊抗兔),即用型 (货号G1302), 室温孵育20分钟. |
| IHC检测MUC6蛋白(货号 GB150033). 样品: 人胃, 4%多聚甲醛 (货号G1101) 固定12-24小时. 抗原修复: 柠檬酸抗原修复液(干粉, pH 6.0) (G1201), 高压锅均匀喷气计时2分钟. —抗: 1: 800稀释, 4℃ 孵育过夜. 二抗: S-vision免疫组化多聚二抗(山羊抗兔),即用型 (货号G1302), 室温孵育20分钟. |
| IF检测MUC6蛋白(货号 GB150033)(红色). 样品: 人胃, 4%多聚甲醛 (货号G1101) 固定12-24小时. 抗原修复: 柠檬酸抗原修复液(干粉, pH 6.0) (G1201), 高压锅均匀喷气计时2分钟. 封闭: 3% BSA(货号GC305010)的PBS溶液, 室温孵育30分钟. —抗: 1: 800稀释, 4℃ 孵育过夜. 二抗: Cy3标记山羊抗兔IgG (H+L) (货号GB21303), 1: 300稀释, 室温孵育1小时. |
| IF检测MUC6蛋白(货号 GB150033)(红色). 样品: 人胃, 4%多聚甲醛 (货号G1101) 固定12-24小时. 抗原修复: 柠檬酸抗原修复液(干粉, pH 6.0) (G1201), 高压锅均匀喷气计时2分钟. 封闭: 3% BSA(货号GC305010)的PBS溶液, 室温孵育30分钟. —抗: 1: 800稀释, 4℃ 孵育过夜. 二抗: Cy3标记山羊抗兔IgG (H+L) (货号GB21303), 1: 300稀释, 室温孵育1小时. |
储存
| 储存条件 | 在-20℃下储存一年, 避免反复冻融. |
| 储存缓冲液 | 含0.15% ProClin300防腐剂, 100 μg/mL牛血清白蛋白和50%甘油的磷酸盐缓冲液. |
注意:
1.本产品仅供研究使用.
2.建议用一抗稀释液(G2025)稀释本产品.
服务推荐
| 货号 | 名称 | 规格 | 价格 | 操作 |
|---|
产品推荐
| 货号 | 名称 | 规格 | 价格 | 操作 |
|---|